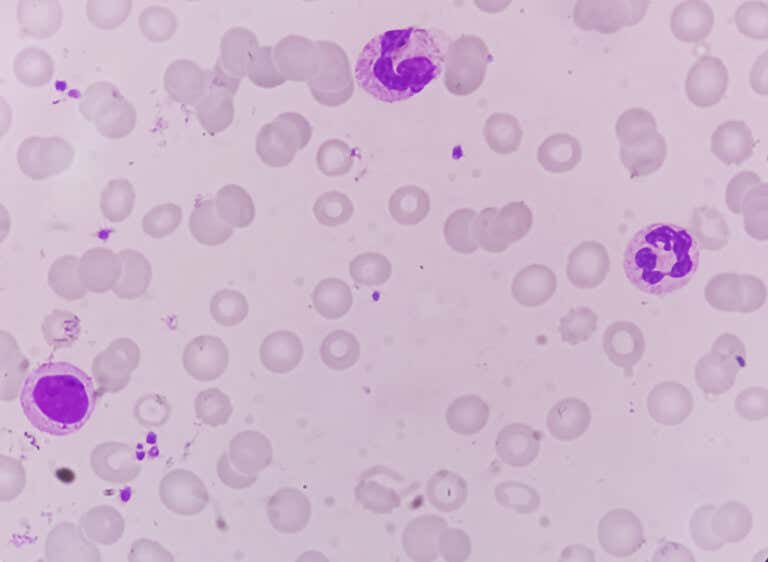
RDW 수치 산소

RDW 혈액 검사는 혈액 검사 일부로 빈혈 및 지중해 빈혈 같은 상태의 진단에 사용된다.
혈액 검사 결과에서 종종 우려되는 변수는 RDW 수치 또는 ‘적혈구 분포 폭’ 수치다. 이는 폐에서 신체의 나머지 세포로 산소를 운반하는 역할을 하는 적혈구 크기의 다양성을 나타내는데 높거나 낮은 RDW 수치의 의미는 무엇일까?
RDW 수치가 높으면 가장 작은 적혈구와 가장 큰 적혈구 크기 사이에 상당한 차이가 있다는 의미다. 이는 일반적으로 많은 적혈구가 정상보다 큰 상황에 적용되지만 반대의 경우도 마찬가지이며 빈혈 진단에 정기적으로 사용한다.
RDW 수치가 평균 적혈구량(MCV) 같은 다른 변수와 같이 낮아야만 질환을 의심할 수 있다. 다음에서 일반 혈액 검사(CBC)에서 이 지표의 중요성을 자세히 설명하겠다.
더 읽어보기: 혈중 피브리노겐 검사 역할과 결과 분석
RDW란?
RDW 또는 적혈구 분포 폭은 혈액 검사로 알 수 있는 매개변수로 적혈구 크기 분포를 반영하며 정상 수치는 12%~15%다.
일반적으로 적혈구 부동증과 유사할 수 있지만 적혈구 부동증은 말초 혈액 도말에서 현미경으로 적혈구를 직접 관찰한 결과다.
더 읽어보기: 고혈압과 스트레스 연관성은 무엇인가?
RDW 수치가 15% 이상이면 혈액에 변화가 있다는 뜻이다. 원인은 비타민 B12 결핍과 알코올 중독 등 매우 다양할 수 있다.
전통적으로 다양한 유형의 빈혈을 진단하는 검사로 지중해 빈혈, 간과 신장 질환, 당뇨병, 일부 혈액 종양 같은 상태를 확인하기 위해 다른 검사와 함께 받기도 한다.
혈액 검사에서 높은 RDW 수치 의미
RDW 수치가 높으면 적혈구 크기에 큰 변화가 있다는 의미다. 헤모글로빈 및 평균 적혈구 용적(MCV) 수치와 함께 해석하여 다양한 유형의 빈혈 또는 기타 질병을 구별한다.
가장 일반적인 원인은 다음과 같다.
- 철 결핍성 빈혈: 철 결핍으로 헤모글로빈이 제대로 합성되지 않아서 헤모글로빈과 평균 적혈구 용적 수치가 감소한다.
- 거대적 아구성 빈혈: 세포 전구체에서 DNA 합성에 필요한 엽산 또는 비타민 B12의 결핍으로 발생한다. 보통 헤모글로빈 수치는 낮고 평균 적혈구 용적 수치가 높다.
- 지중해 빈혈: 비정상적인 형태의 헤모글로빈이 합성되는 유전 질환으로 헤모글로빈과 평균 적혈구 용적 수치가 모두 낮다.
- 간 질환 : 신진대사와 노폐물 제거 관련 간 기능이 손상되고 적혈구 크기가 변경되는 경우가 많다.
‘Plos One’ 저널에 발표된 연구 결과를 보면 높은 RDW 수치는 제2형 당뇨병, 특히 심부전 같은 심혈관 질환, 암 등의 만성 질환이 있다는 의미로 해석할 수 있다.
현재 RDW 수치를 정상으로 복원하는 특별한 치료법은 없다. 적절하고 효과적인 프로토콜을 따르기 위해서는 변화를 일으키는 질병의 진단을 받는 것이 필수다.
높은 RDW 수치를 낮추기 위한 권장 사항
RDW 수치를 낮추려면 근본 원인에 개입해야 한다. 치료법은 관련 질병에 따라 다르지만 정상값으로 복원하는 데 도움이 되는 몇 가지 참고 사항은 아래와 같다.
더 읽어보기: 종양학적 혈액 검사 효과 및 유용성
낮은 RDW 수치
낮은 RDW 수치는 임상적으로 의미가 없다. 특히 헤모글로빈 및 평균 적혈구 용적이 변하지 않았다면 질병을 나타내지 않는다.
그러나 평균 적혈구 용적에 변화가 있고 RDW 수치가 낮다면 신장 질환, HIV, 암, 당뇨병, 간 질환 유무를 추가 검사로 확인할 수 있다.
빈혈을 나타낼 수 있는 높은 RDW 수치
여러 질환으로 RDW 수치가 증가할 수 있지만 대부분 철 결핍성 빈혈, 거대적 아구성 빈혈 등의 결핍성 빈혈과 관련이 있다. 또한 지중해 빈혈, 간 질환 및 기타 만성 질환을 나타낼 수도 있다.
어떤 경우이든 이러한 변화 뒤에 어떤 질병이 있는지 확인하는 의학적 치료를 받는 것이 중요하다. 확인 후 적절한 치료법을 정해야 한다.
인용된 모든 출처는 우리 팀에 의해 집요하게 검토되어 질의의 질, 신뢰성, 시대에 맞음 및 타당성을 보장하기 위해 처리되었습니다. 이 문서의 참고 문헌은 신뢰성이 있으며 학문적 또는 과학적으로 정확합니다.
-
Fava, C., Cattazzo, F., Hu, Z. D., Lippi, G., & Montagnana, M. (2019). The role of red blood cell distribution width (RDW) in cardiovascular risk assessment: useful or hype? Annals of Translational Medicine, 7(20), 581. https://www.ncbi.nlm.nih.gov/pmc/articles/PMC6861793/
-
Hu, Z., Sun, Y., Wang, Q., Han, Z., Huang, Y., Liu, X., Ding, C., Hu, C., Qin, Q., & Deng, A. (2013). Red blood cell distribution width is a potential prognostic index for liver disease. Clinical Chemistry and Laboratory Medicine, 51(7), 1403–1408. https://pubmed.ncbi.nlm.nih.gov/23314558/
- Loprinzi, P. D. (2015). Sleep duration and sleep disorder with red blood cell distribution width. American Journal of Health Behavior, 39(4), 471–474. https://doi.org/10.5993/AJHB.39.4.3
- Loprinzi, P. D., Loenneke, J. P., & Abe, T. (2015). The association between muscle strengthening activities and red blood cell distribution width among a national sample of U.S. adults. Preventive Medicine, 73(1), 130–132. https://doi.org/10.1016/j.ypmed.2015.01.011
- Said, A. S., Spinella, P. C., Hartman, M. E., Steffen, K. M., Jackups, R., Holubkov, R., Wallendorf, M., & Doctor, A. (2017). RBC Distribution Width: Biomarker for Red Cell Dysfunction and Critical Illness Outcome? Pediatric Critical Care Medicine: a journal of the Society of Critical Care Medicine and the World Federation of Pediatric Intensive and Critical Care Societies, 18(2), 134–142. https://www.ncbi.nlm.nih.gov/pmc/articles/PMC5291765/
- Sharma, D. (2015). Significance of red cell distribution width in the diagnosis of iron deficiency anemia: An observational study from India. Journal of Pediatrics & Neonatal Care, 3(1), 62–65. https://doi.org/10.15406/jpnc.2015.02.00102